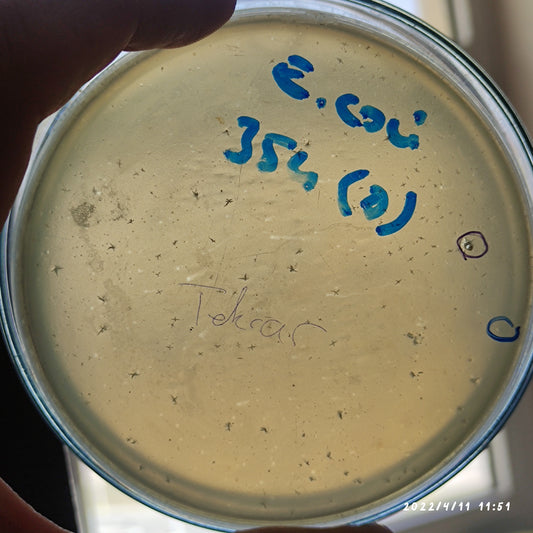
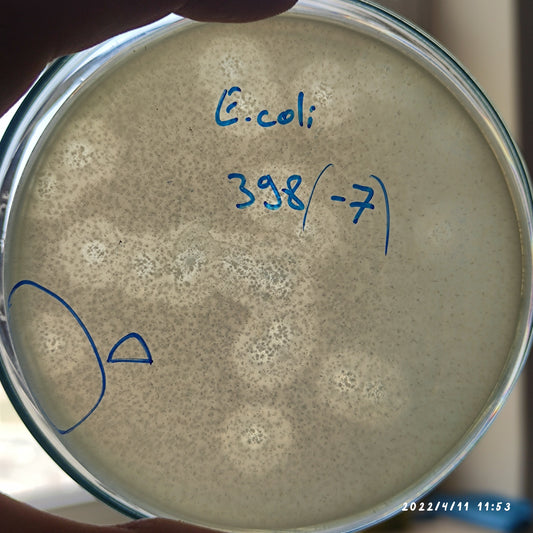
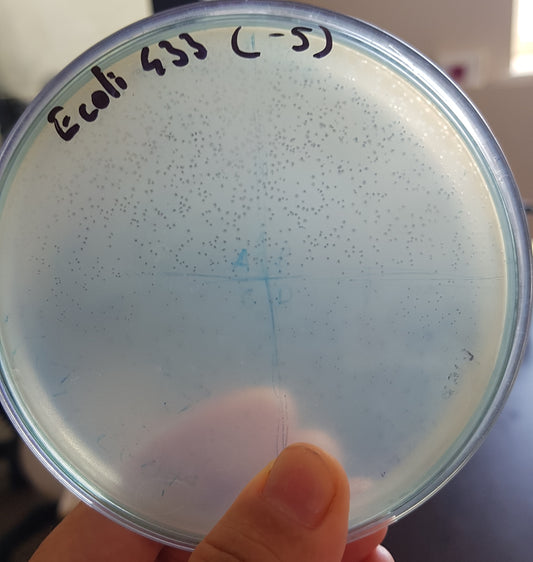
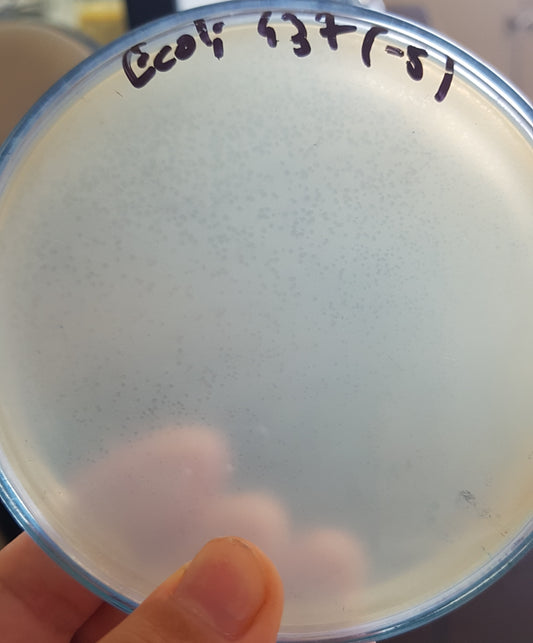
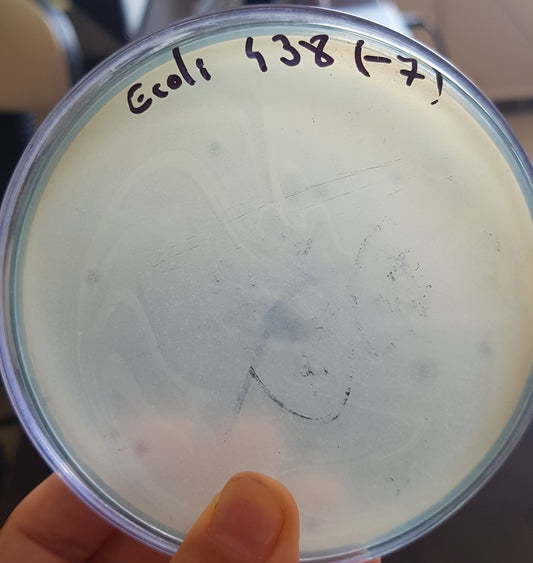
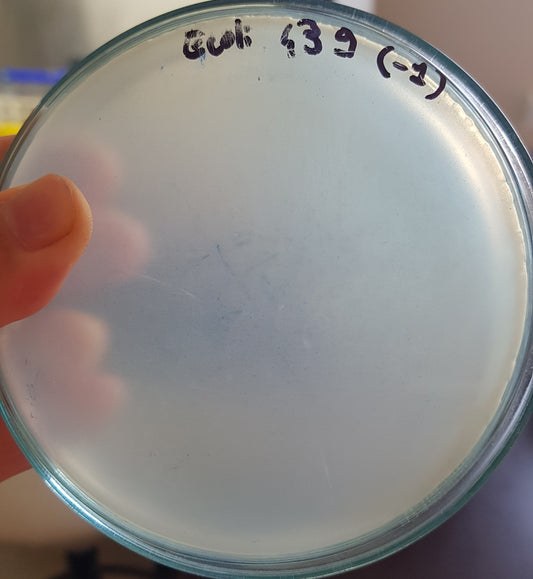
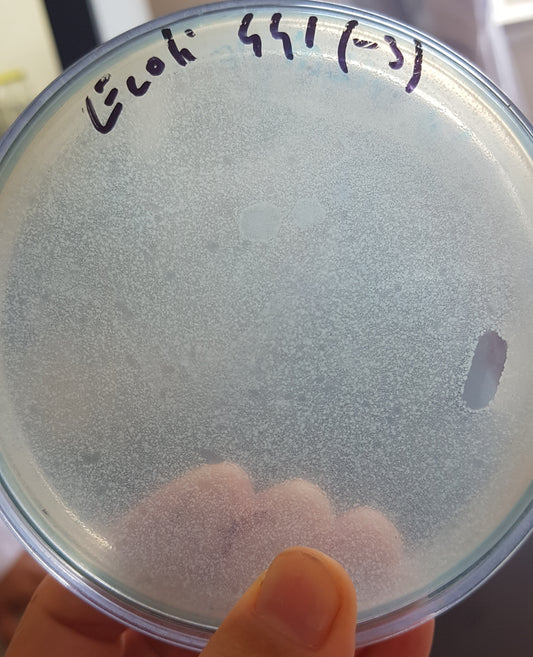
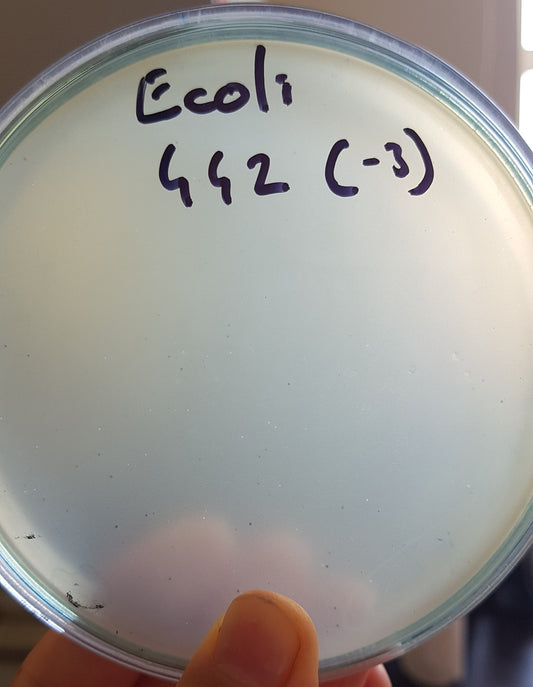
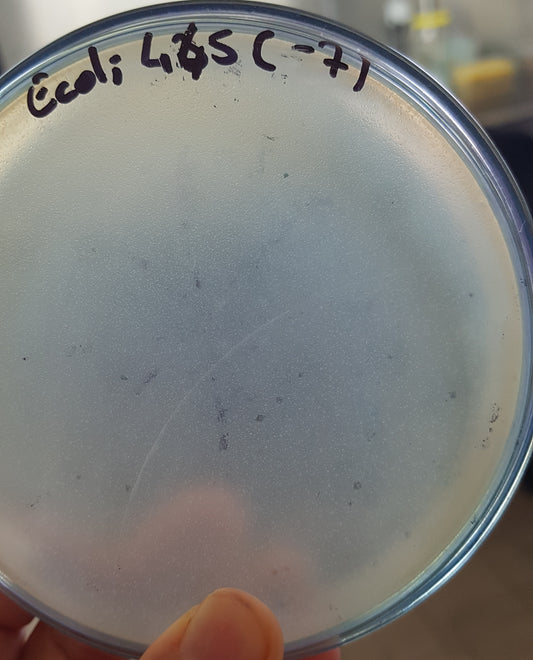
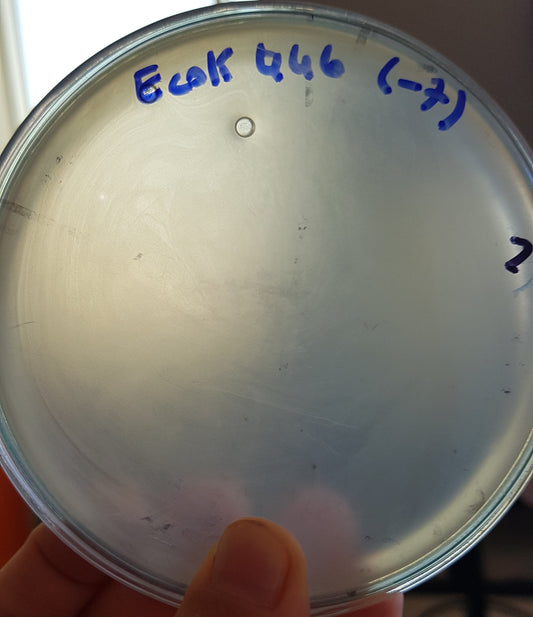

-
Escherichia coli bacteriophage 100354D
Regular price $500.00 USDRegular priceUnit price per -
Escherichia coli bacteriophage 100398D
Regular price $900.00 USDRegular priceUnit price per -
Escherichia coli bacteriophage 100431A
Regular price $500.00 USDRegular priceUnit price per -
Escherichia coli bacteriophage 100433A
Regular price $500.00 USDRegular priceUnit price per -
Escherichia coli bacteriophage 100437A
Regular price $500.00 USDRegular priceUnit price per -
Escherichia coli bacteriophage 100438A
Regular price $500.00 USDRegular priceUnit price per -
Escherichia coli bacteriophage 100439A
Regular price $500.00 USDRegular priceUnit price per -
Escherichia coli bacteriophage 100440A
Regular price $500.00 USDRegular priceUnit price per -
Escherichia coli bacteriophage 100441A
Regular price $500.00 USDRegular priceUnit price per -
Escherichia coli bacteriophage 100442A
Regular price $500.00 USDRegular priceUnit price per -
Escherichia coli bacteriophage 100443A
Regular price $500.00 USDRegular priceUnit price per -
Escherichia coli bacteriophage 100444A
Regular price $500.00 USDRegular priceUnit price per -
Escherichia coli bacteriophage 100445A
Regular price $500.00 USDRegular priceUnit price per -
Escherichia coli bacteriophage 100446A
Regular price $500.00 USDRegular priceUnit price per -
Escherichia coli bacteriophage 100447A
Regular price $650.00 USDRegular priceUnit price per -
Escherichia coli bacteriophage 100448A
Regular price $500.00 USDRegular priceUnit price per